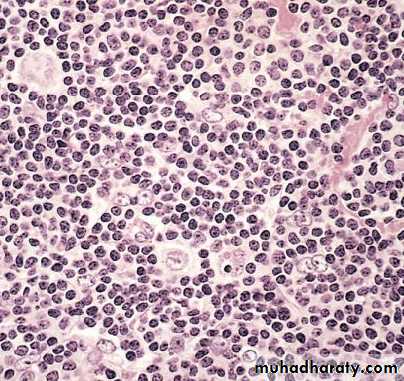
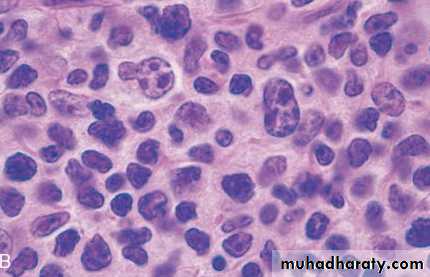

Malignant lymphoma
Nodular Sclerosis Type.This is the most common form of HL
deposition of collagen in bands that divide involved lymph nodes into circumscribed nodules
lacunar variant Reed-Sternberg cells
Most common subtype(65%)
frequent mediastinal involvement;equal occurrence in males and females (F = M), most patients young adults
Mixed cellularity
More than 50% present as stage III or IV disease;M greater than F
peaking in young adults and again in adults older than 55Y
Frequent mononuclear and diagnostic RS cells; background infiltrate rich in T lymphocytes, eosinophils, macrophages, plasma cells; RS
Lymphocyte rich
Uncommon; M greater than F; tends to be seen in older adultsFrequent mononuclear and diagnostic RS cells; background infiltrate rich in T lymphocytes
Lymphocyte depletion
more common in older males, HIV-infected individuals, and in developing countries; often presents with advanced disease
Reticular variant: Frequent diagnostic RS cells and variants and a paucity of background
Lymphocyte predominanceUncommon; young males with cervical or axillary lymphadenopathy; mediastinal
Frequent L&H (popcorn cell) variants in a background of follicular dendritic cells and reactive B cells;Complication of HODGKIN LYMPHOMA
Depression of cell mediated immunity even after successful treatment.Long term survivors after chemotherapy or radiotherapy have higher risk of developing second cancer( AML, Myelodysplastic Syndrome, lung, breast stomach & skin cancers).
If untreated, death within 2 year . With modern chemotherapy, 85% cure rate.
Non-Hodgkin`s lymphoma
General characters:1.Monoclonal proliferation of single transformed cell arrested at a certain stage during transformation (or differentiation) with variable behaviour.
Lymphoid stem cells –Pre B cells—mature (peripheral) B cells—plasma cells.
Lymphoid stem cell—pre T—mature T (thymocyte).
2. Can be nodal (2/3rd) or extranodal (1/3rd).
3.More than 80% are of B cell type.
4- They are heterogeneous group of tumors with wide range of clinical behavior (from low to high grade)
5 - Low grades , grow slowly, are often disseminated . High grade are usually localised , grow rapidly & respond to chemotherapy
6- Immunophenotyping by the use of monoclonal antibodies (C D system)
NHL-Classification ( W H O – 2001 )Four main categories:
1. Pre-B cell neoplasms (lymphoblastic ALL).
2. Pre-T cell neoplasms (lymphoblastic).
3. Peripheral B cell neoplasms.
4. Peripheral T cell neoplasms.
Pattern of growth in some B cell lymphomas can be follicular / or diffuse.
NHL- Classification
I. Precursor B-Cell Neoplasms
Precuror-B lymphoblastic leukaemia/lymphoma.
II. Peripheral B-cell Neoplasms
Chronic lymphocytic leukaemia/small lymphocytic lymphoma.
B-cell prolymphocytic leukaemia
Lymphoblastic lymphoma
Splenic and nodal marginal zone lymphoma
Extranodal marginal zone lymphoma
Mantle cell lymphoma
Follicular lymphoma
Marginal zone lymphoma /MALT lymphoma
Hairy cell leukaemia
Plasmacytoma/plasma cell myeloma
Diffuse large B-cell lymphoma
Burkitt`s lymphoma
NHL-Classification
IV. Peripheral T-Cell and NK-Cell NeoplasmsT-cell prolymphocytic leukaemia
Large granular lymphocytic leukaemia
Mycosis fungoides/Sezary syndrome
Peripheral T-cell lymphoma,unspecified
Anaplastic large cell lymphoma
Angioimmunoblastic T-cell lymphoma
Enteropathy-associated T-cell lymphoma
Panniculitis-like T-cell lymphoma
Hepatosplenic T-cell lymphoma
Adult T-cell leukaemia/lymphoma
NK/T-cell lymphoma nasal type
NK-cell leukaemia
V. Hodgkin`s lymphoma
NHL-Examples
Tumours of Pre B and Pre T cells(Lymphoblastic lymphomas):
Both:
Affect children, of high grade of malignancy.Cure is possible with aggressive chemotherapy.
Lymphoma/leukaemia picture.
Involvement of extranodal sites (testis, CNS ,liver).
85% of B = ALL.
T = Thymic mass.
NHL- Peripheral B cell lymphomas
CLL (lymphoma/leukaemia):Diffuse lymphoma of small lymphocytes.
L<4000/mm (absolute count in peripheral blood).
Most common lymphoma in adults. GLA, hepato splenomegaly with BM involvement.
Low grade malignancy but may progress to Richter`s syndrome (high grade)
NHL-Peripheral B cell lymphoma
Burkitt`s Lymphoma: Two main types :1. Endemic due to EBV infection.
2. Non endemic.
Both occur in children & young adults ,mainly in extranodal sites.
Both are associated with Translocation 8:14 and activation of c-myc(transcrptional proto oncogen).
Organs of involvement : GIT, ovary, mandible .
NHL-Peripheral B cell lymphoma
Follicular lymphoma :
Most common type in western countries.
Very uncommon in Iraq.
Always nodal, of low grade of malignancy.
Associated with translocation 14:18(apoptosis regulating gene).
M A L T lymphoma ( MALToma)
Low grade B cell lymphoma.(of marginal zone)Usually in epithelial-containing Extranodal sites (GIT, Salivary gland, Thyroid, lacrimal gland, lung, etc.,)
May occur as a complication of autoimmune conditions (e.g. Sjogren’ syndrome, Hashimoto’ thyroiditis)
Remain localised for a long time then may recur in another epithelial containing ENS
Treatment is usually surgical.
Thymus
Composed of lymphocytes & specialized epithelial cells (Hassall corpuscles).Functions: development of T cells
Absence leads to deficiency of T cell mediated immunity.
Tumors :lymphomas, germ cell tumors, neuroendocrine tumors (may be functional).
Thymomas from epithelial componants:
80% are benign ,10% low grade of malignancy ,10% show metastasis.
May be associated with mysthenia gravis, red cell aplasia & autoimmune conditions.(usually in association with hyperplasia)